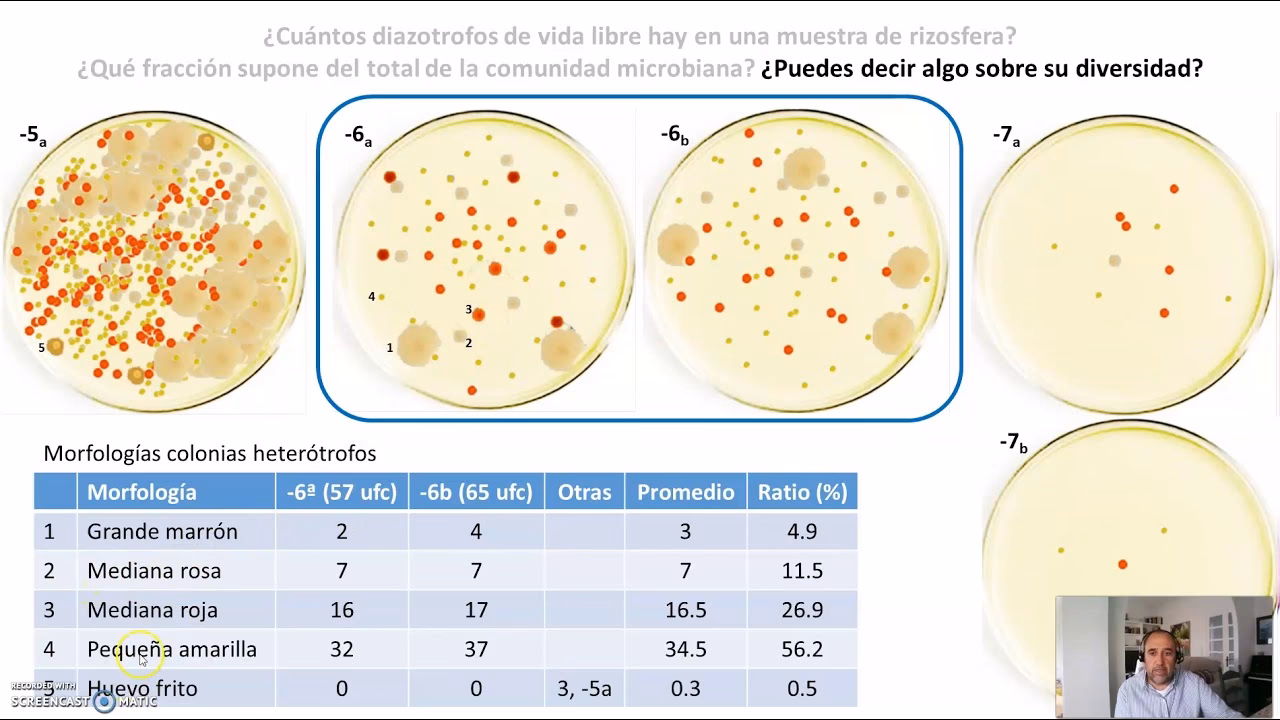
¿Cómo se calculan las UFC?

08/06/2024
En el vasto y complejo universo de la microbiología, comprender la cantidad de microorganismos presentes en una muestra es fundamental para una miríada de aplicaciones, desde la investigación científica y el desarrollo de medicamentos hasta el control de calidad en la industria alimentaria. Una de las métricas más importantes y ampliamente utilizadas para cuantificar bacterias y hongos viables es la Unidad Formadora de Colonias, comúnmente abreviada como UFC (o CFU, por sus siglas en inglés, Colony Forming Unit). Este artículo se adentrará en el significado de las UFC, cómo se calculan, por qué son tan relevantes y cómo su medición impacta directamente en nuestra seguridad y bienestar, prestando especial atención a su aplicación en la industria láctea.

Las UFC no son simplemente un número; representan una estimación de las células microbianas que son capaces de reproducirse y formar una colonia visible en un medio de cultivo adecuado. A diferencia de un conteo total de células, que incluye tanto células vivas como muertas, las UFC se centran exclusivamente en los microorganismos viables, es decir, aquellos que tienen el potencial de crecer y multiplicarse. Esta distinción es crucial para evaluar la calidad microbiana de una muestra y predecir su comportamiento.
- ¿Qué son las Unidades Formadoras de Colonias (UFC)?
- La Ciencia Detrás del Conteo: ¿Cómo se Calculan las UFC?
- El Proceso de Medición: ¿Cómo se Miden las UFC en el Laboratorio?
- UFC en la Vida Cotidiana: Calidad y Seguridad Alimentaria, Especialmente en Productos Lácteos
- Factores Clave que Influyen en los Conteos de UFC
- Estrategias para Mantener Bajos los Conteos de UFC en Leche
- Preguntas Frecuentes (FAQ) sobre las UFC
¿Qué son las Unidades Formadoras de Colonias (UFC)?
Las Unidades Formadoras de Colonias (UFC) son una unidad de medida estándar utilizada en microbiología para cuantificar el número de microorganismos viables (bacterias o levaduras/mohos) presentes en una muestra determinada. Un microorganismo se considera viable si es capaz de crecer y reproducirse bajo condiciones específicas de laboratorio, dando lugar a una colonia macroscópicamente visible en un medio de cultivo sólido, como una placa de agar.
El concepto se basa en la premisa de que, en condiciones ideales, una única célula microbiana viable puede dividirse y multiplicarse repetidamente para formar una aglomeración de células (una colonia) que es visible a simple vista. Por lo tanto, al contar estas colonias en una placa de cultivo, los microbiólogos pueden estimar la concentración de microorganismos viables en la muestra original. Esta medida es vital para evaluar la eficacia de los tratamientos antimicrobianos, la calidad de los productos farmacéuticos, la seguridad alimentaria y la salud ambiental.
La unidad de medida se expresa típicamente como UFC/mL para muestras líquidas (como suspensiones bacterianas, agua o leche) y UFC/g para muestras sólidas (como alimentos o suplementos probióticos). La precisión en la determinación de las UFC es un pilar para la investigación, el diagnóstico y el control de calidad en numerosos campos.
La Ciencia Detrás del Conteo: ¿Cómo se Calculan las UFC?
El cálculo de las UFC es un proceso que combina el conteo de colonias en una placa de cultivo con un factor de dilución. Dado que muchas muestras originales son demasiado concentradas para permitir un conteo preciso de colonias, es común realizar una serie de diluciones en serie antes de sembrar la muestra en las placas de agar. Este proceso asegura que al menos una de las diluciones resulte en un número contable de colonias, que generalmente se encuentra entre 30 y 300 para una precisión óptima en una placa estándar de 10 cm de diámetro.
La fórmula general para calcular las UFC por mililitro (UFC/mL) o por gramo (UFC/g) es la siguiente:
UFC/ml = (Número de colonias contadas × Factor de dilución) / Volumen de la muestra sembrada (en mL)Donde:
- Número de colonias contadas: Es el número de colonias visibles en la placa de agar seleccionada.
- Factor de dilución: Es el inverso de la dilución total de la muestra que se sembró en la placa. Por ejemplo, si se hizo una dilución de 10-6 (es decir, una parte de la muestra original se diluyó un millón de veces), el factor de dilución sería 106.
- Volumen de la muestra sembrada: Es la cantidad de la muestra diluida que se colocó en la placa de agar, generalmente expresada en mililitros (mL). El volumen más común para siembra en placa es 0.1 mL o 1 mL.
Ejemplo Práctico de Cálculo de UFC
Para ilustrar cómo se aplica esta fórmula, consideremos el siguiente escenario:
Supongamos que tenemos una muestra líquida (por ejemplo, una suspensión bacteriana). Realizamos una serie de diluciones y sembramos 0.1 mL de una dilución 10-5 en una placa de agar. Después de la incubación, contamos 85 colonias visibles en esa placa.

Aplicando la fórmula:
- Número de colonias contadas = 85
- Factor de dilución = 105 (ya que la dilución fue 10-5)
- Volumen de la muestra sembrada = 0.1 mL
UFC/mL = (85 × 105) / 0.1
UFC/mL = 8,500,000 / 0.1
UFC/mL = 85,000,000
Esto significa que la concentración de microorganismos viables en la muestra original es de 8.5 x 107 UFC/mL. Este ejemplo demuestra cómo un número relativamente pequeño de colonias contadas puede representar una gran cantidad de microorganismos en la muestra original gracias al proceso de dilución y el factor de amplificación que este implica.
El Proceso de Medición: ¿Cómo se Miden las UFC en el Laboratorio?
La medición de las UFC es un procedimiento estándar en cualquier laboratorio de microbiología. Comienza con la preparación de la muestra, que a menudo implica la realización de diluciones en serie. Este paso es crucial para asegurar que la concentración de microorganismos en las placas finales no sea ni demasiado alta (lo que haría imposible contar colonias individuales) ni demasiado baja (lo que resultaría en pocas o ninguna colonia, dificultando la estadística).
El proceso generalmente sigue estos pasos:
- Preparación de Diluciones en Serie: La muestra original se diluye progresivamente en una serie de tubos, típicamente en factores de 10 (por ejemplo, 1:10, 1:100, 1:1000, y así sucesivamente). Cada dilución se mezcla a fondo para asegurar una distribución homogénea de los microorganismos.
- Siembra en Placa: Una alícuota de cada dilución (comúnmente 0.1 mL o 1 mL) se transfiere a una placa de Petri que contiene un medio de cultivo sólido (agar). Existen dos métodos principales de siembra:
- Siembra en Superficie (Spread Plate): La muestra se extiende sobre la superficie del agar solidificado y se deja absorber.
- Siembra en Profundidad (Pour Plate): La muestra se mezcla con el agar fundido (enfriado a una temperatura que no dañe los microorganismos) antes de que solidifique, distribuyendo las células por todo el medio.
- Incubación: Las placas sembradas se incuban en condiciones controladas de temperatura y tiempo, que son óptimas para el crecimiento de los microorganismos en cuestión. Durante este período, cada célula viable dará lugar a una colonia visible.
- Conteo de Colonias: Una vez transcurrido el tiempo de incubación, se seleccionan las placas que presentan un número contable de colonias (idealmente entre 30 y 300). Este rango es el más adecuado porque menos de 30 colonias puede llevar a errores estadísticos significativos, mientras que más de 300 hace que el conteo sea impreciso debido a la superposición y dificultad para distinguir colonias individuales. El conteo se realiza manualmente o con la ayuda de contadores de colonias automáticos.
- Cálculo de UFC/mL o UFC/g: Finalmente, el número de colonias contadas se utiliza en la fórmula mencionada anteriormente, junto con el factor de dilución y el volumen sembrado, para determinar la concentración de UFC en la muestra original.
Este meticuloso proceso asegura una estimación confiable y reproducible de la población microbiana viable, siendo una herramienta indispensable en el control de calidad microbiológico.
UFC en la Vida Cotidiana: Calidad y Seguridad Alimentaria, Especialmente en Productos Lácteos
Aunque el concepto de UFC pueda parecer puramente científico, su aplicación tiene un impacto directo en nuestra vida diaria, especialmente en la calidad láctea y la seguridad alimentaria. Los recuentos de UFC son un indicador fundamental de la calidad higiénica de la leche cruda y, por extensión, de los productos lácteos que consumimos.
La leche es un medio extremadamente nutritivo para el crecimiento de microorganismos. Una leche de buena calidad higiénica es aquella que posee un bajo recuento bacteriano (UFC/mL), lo que indica que ha sido producida, recolectada y almacenada bajo condiciones óptimas de higiene. Por el contrario, altos conteos de UFC en la leche cruda son una señal de alarma, sugiriendo deficiencias en la limpieza, la desinfección o el mantenimiento de la cadena de frío.
Para la industria láctea y los consumidores, la calidad de la leche se traduce en:
- Seguridad Alimentaria: Un bajo recuento de UFC minimiza el riesgo de presencia de bacterias patógenas que pueden causar enfermedades.
- Mayor Vida Útil: Menos microorganismos iniciales significan que el producto tardará más en descomponerse, prolongando su frescura y sabor.
- Calidad Organoléptica: Las bacterias pueden alterar el sabor, olor y textura de la leche y sus derivados. Un buen control de UFC asegura que el producto mantenga sus características deseables.
- Eficiencia en el Procesamiento: La leche con altos conteos bacterianos puede causar problemas en los procesos de pasteurización y elaboración de otros productos lácteos, afectando la calidad del producto final.
Generalmente, una leche de buena calidad microbiológica se define como aquella que contiene menos de 10,000 UFC/mL. Superar este umbral puede implicar sanciones para los productores y un riesgo para la salud pública si no se procesa adecuadamente.

La Importancia de la Calidad Higiénica de la Leche Cruda
La calidad de los productos lácteos comienza en la granja. No es posible obtener productos lácteos de alta calidad a partir de leche cruda de mala calidad. El Recuento Bacteriano (UFC/mL) es uno de los dos parámetros clave, junto con el Recuento de Células Somáticas (RCS), que tradicionalmente se utilizan para evaluar la calidad higiénica de la leche cruda. Mientras que el RCS indica la salud de la ubre de la vaca, el recuento de UFC es un indicador directo de la cantidad de microorganismos vivos en la leche y, por lo tanto, evalúa las condiciones higiénicas de extracción y almacenamiento.
Una leche de buena calidad debe cumplir con varias características, incluyendo una composición adecuada, ausencia de microorganismos patógenos y toxinas, no contener agua añadida ni residuos químicos, y tener un mínimo de microorganismos saprofitos y células somáticas, además de características organolépticas adecuadas. El control de las UFC es fundamental para cumplir con estos estándares.
Factores Clave que Influyen en los Conteos de UFC
Mantener bajos los conteos de UFC en la leche es un desafío constante que requiere una atención meticulosa a múltiples factores a lo largo de toda la cadena de producción. Los altos conteos de UFC suelen ser un reflejo directo de deficiencias en la higiene o en el manejo de la temperatura. A continuación, se detallan los principales factores:
1. Higiene de la Vaca y su Entorno
La limpieza de la vaca y el ambiente donde se aloja y se ordeña son cruciales. Las ubres sucias, el estiércol, el barro y la falta de limpieza en los caminos, patios de espera y cubículos pueden introducir una gran cantidad de bacterias directamente en la leche. Unos procedimientos pre-ordeño deficientes, como no limpiar y secar adecuadamente los pezones, o no realizar el despunte (eliminar los primeros chorros de leche que contienen una alta carga bacteriana), contribuyen significativamente a la contaminación. Se recomienda cortar el pelo de la cola y flamear el vello de la ubre regularmente para reducir la suciedad que puede caer en la leche.
2. Higiene del Equipo de Ordeño y Estanque de Frío
El equipo de ordeño y los tanques de almacenamiento son superficies de contacto directo con la leche y, por lo tanto, una fuente potencial masiva de contaminación si no se limpian y desinfectan adecuadamente. Los residuos de leche que quedan en las superficies, especialmente en grietas o en piezas de goma viejas y agrietadas, favorecen el crecimiento de microorganismos y la formación de biopelículas, que son muy difíciles de eliminar. Un mal lavado, con temperaturas inadecuadas o sin detergentes efectivos, permite que los microorganismos se multipliquen. Además, la calidad del agua utilizada para el lavado y enjuague del equipo es fundamental; debe ser de la misma seguridad y pureza que el agua potable.
3. Temperatura y Tiempo de Almacenamiento
La leche es un caldo de cultivo ideal para las bacterias. Si no se enfría rápidamente a la temperatura adecuada (idealmente 4°C) y se mantiene refrigerada, las bacterias presentes se multiplicarán exponencialmente en muy poco tiempo. Un aumento de tan solo unos pocos grados o un retraso en el enfriamiento puede llevar a un incremento masivo en el recuento de UFC, comprometiendo gravemente la calidad y seguridad de la leche.
Estrategias para Mantener Bajos los Conteos de UFC en Leche
Para garantizar una leche de alta calidad con bajos conteos de UFC, es imprescindible implementar y mantener un protocolo estricto de higiene y control en todas las etapas de la producción. A continuación, se presenta una tabla resumen con las acciones clave:
| Área | Acciones Clave para Reducir UFC |
|---|---|
| Higiene de la Vaca y Entorno |
|
| Higiene del Equipo de Ordeño |
|
| Manejo de la Leche |
|
La implementación de estas medidas, junto con un monitoreo constante de los conteos de UFC, es esencial para asegurar la producción de leche de la más alta calidad y seguridad para el consumidor.
Preguntas Frecuentes (FAQ) sobre las UFC
A continuación, abordamos algunas de las preguntas más comunes relacionadas con las Unidades Formadoras de Colonias:
¿Qué significa un alto conteo de UFC?
Un alto conteo de UFC en una muestra, especialmente en alimentos como la leche, generalmente indica una higiene deficiente en el proceso de producción o almacenamiento, o una interrupción en la cadena de frío. En el contexto de un laboratorio, un conteo inesperadamente alto podría señalar una contaminación en la muestra o en los reactivos. En cualquier caso, sugiere una mayor presencia de microorganismos viables que podrían comprometer la calidad, la seguridad o la estabilidad del producto o la muestra.
¿Por qué es importante el rango de 30 a 300 colonias para el conteo?
Este rango se considera estadísticamente el más fiable para el conteo de colonias en una placa de agar estándar. Si hay menos de 30 colonias, cualquier error en el conteo de una o dos colonias tendrá un impacto porcentual muy grande en el resultado final, aumentando la variabilidad y disminuyendo la precisión. Si hay más de 300 colonias, es muy difícil distinguir y contar cada colonia individualmente debido a la superposición y la aglomeración, lo que lleva a subestimaciones y errores. El rango de 30-300 permite un equilibrio entre la precisión y la factibilidad del conteo.
¿Las UFC solo se aplican a bacterias?
No, el concepto de Unidades Formadoras de Colonias se aplica tanto a bacterias como a hongos (levaduras y mohos). Siempre que un microorganismo sea capaz de crecer y formar una colonia visible en un medio de cultivo sólido, su concentración puede ser estimada en términos de UFC. La metodología puede variar ligeramente (por ejemplo, diferentes medios de cultivo o temperaturas de incubación) dependiendo del tipo de microorganismo que se desee cuantificar.
¿Cómo impacta la dilución en el cálculo de UFC?
La dilución es fundamental. Sin diluciones, la mayoría de las muestras ambientales o biológicas tendrían un número inmanejable de microorganismos, resultando en placas con un crecimiento tan denso que sería imposible contar colonias individuales (conocido como 'césped' o 'confluencia'). Las diluciones en serie reducen la concentración de microorganismos en la muestra sembrada, permitiendo que las colonias se desarrollen de manera discreta y contable. El factor de dilución es el multiplicador que permite extrapolar el número de colonias contadas en una pequeña porción de la muestra diluida a la concentración original de la muestra sin diluir.
¿Qué es el 'factor de dilución'?
El factor de dilución es el inverso de la dilución total realizada sobre la muestra. Por ejemplo, si una muestra se diluye 1:100,000 (lo que se expresa como 10-5), el factor de dilución es 100,000 (o 105). Este factor se utiliza en la fórmula de cálculo de UFC para escalar el número de colonias contadas en una pequeña porción diluida hasta representar la concentración original de la muestra. Es esencial para obtener un resultado preciso que refleje la cantidad real de microorganismos en la muestra inicial.
En resumen, el cálculo de las UFC es una técnica poderosa y esencial en la microbiología, que nos permite cuantificar la vida microbiana viable de una manera que tiene implicaciones directas en la salud pública, la seguridad alimentaria y la investigación científica. Su correcta aplicación y comprensión son vitales para garantizar la calidad y seguridad en numerosos productos y procesos.
Si quieres conocer otros artículos parecidos a UFC: Entendiendo las Unidades Formadoras de Colonias puedes visitar la categoría Cálculos.
